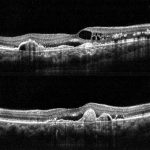
Tomografía

OCT-Tomografía Coherencia Óptica
OCT-Tomografía Coherencia Óptica es en la actualidad una herramienta indispensable en la práctica oftalmológica, es una técnica de diagnóstico, control y seguimiento, que nos permite el estudio de cortes histológicos en vivo de la retina y la córnea. Esta tecnología se basa en un principio óptico complejo denominado interferometría
La OCT-Tomografía Coherencia Óptica es una técnica inocua para el paciente, rápida y de gran fiabilidad y reproductibilidad.
La OCT-Tomografía Coherencia Óptica se emplea en:
La OCT-Tomografía Coherencia Óptica es una técnica inocua para el paciente, rápida y de gran fiabilidad y reproductibilidad.
La OCT-Tomografía Coherencia Óptica se emplea en:
- Estudio de la mácula, estructura de la retina responsable de la máxima agudeza visual. La OCT nos permite realizar cortes histológicos de la retina, desde la cara anterior a la posterior y analizarla microscópicamente, permitiéndonos observar los cambios patológicos que produzcan. Es una prueba fundamental en el seguimiento de pacientes con Degeneración macular asociada a la edad (DMAE), edema macular diabético, edema macular secundaria a trombosis, agujero macular, membrana epirretiniana, tracciones vítreo-maculares, coroidopatía serosa central, etc.
- Glaucoma, la OCT-Tomografía Coherencia Óptica nos permite estudiar la cabeza del nervio óptico y la capa de fibras nerviosas, gracias a su gran precisión, fiabilidad y reproductibilidad nos permite apoyarnos para realizar el diagnóstico y lo que es más importante en esta patología, nos permite realizar un seguimiento del daño producido en el tiempo del glaucoma.
- Córnea, la OCT-Tomografía Coherencia Óptica nos permite realizar cortes completos de la córnea, que nos permite obtener la paquimetría corneal, estudiar las cicatrices y su profundidad.